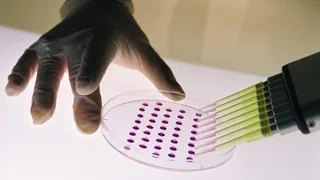

Espresso aktuell
Kassensturz aktuell
Aktuelle Betrugsfälle
Alle Kassensturz Sendungen
Tests
Die unabhängigen Produkte-Tests von «Kassensturz» gibt es einmal pro Woche neu.
Kassensturz «Im Ärnscht?»
Alltagsgeschichten zum Ärgern, Staunen und auch zum Schmunzeln
Gerade aktuell oder kürzlich gesendet
Kontakt
Experten-Chats
Expertinnen und Experten beantworten Ihre Fragen